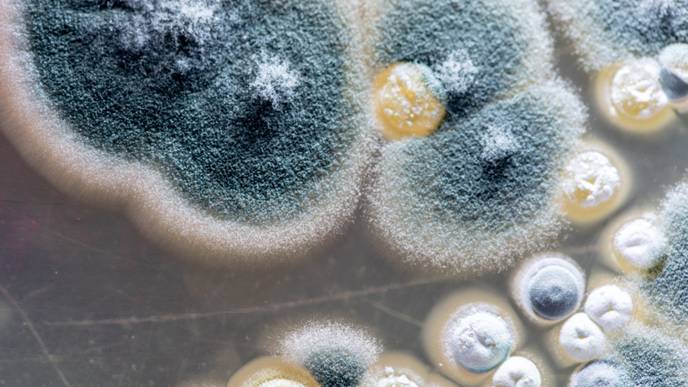
ReachMD Healthcare Image

Fungal Spores of the Mold Aspergillus Fumigatus Produce an Enzyme That Weakens the Immune System
by Friederike Gawlik, Leibniz-Institut für Naturstoff-Forschung und Infektionsbiologie - Hans-Knöll-Institut (Leibniz-HKI)
Aspergillus fumigatus is a mold that is found all over the world. Unlike closely related species, it can cause serious, often fatal infections in humans. What makes A. fumigatus so dangerous? An international research team led by Gustavo Goldman from the University of São Paulo in Brazil has found clues to the cause.
A special enzyme on the surface of the fungal spores—glycosylasparaginase—apparently suppresses the release of pro-inflammatory substances by immune cells, making it easier for the pathogen to spread unhindered in the tissue. The findings are published in the journal Nature Microbiology.
"Gustavo Goldman's group was particularly interested in the surface proteins on the spores, as these are the first to come into contact with the immune system—usually through inhalation," reports Olaf Kniemeyer from the Leibniz Institute for Natural Product Research and Infection Biology—Hans Knöll Institute (Leibniz-HKI), the German partner of the study.
Kniemeyer is a proteomics expert. Together with his team, he analyzes all the proteins in a cell and assigns functions to them. This is how he finds potential targets for new active substances. The researchers from Jena also specialize in phagocytosis, a defense mechanism in which immune cells devour foreign invaders. This also enabled the international research team to study the interaction of the fungus with immune cells.
In the current study, they used an approach called trypsin shaving: with the help of trypsin, a protein-cleaving enzyme, they removed all proteins from the spore surface and analyzed their fragments in a mass spectrometer.
Using database comparisons, they were able to identify 62 proteins that only occur on the spores of Aspergillus fumigatus, but not on closely related species. Some of them could therefore play a role in the infection process.
To test this, the researchers created a knockout library with 42 mutants of the fungus, in each of which a gene coding for one of these proteins was switched off. The mutant that lacked the glycosylasparaginase triggered an increased release of interleukin-1β in immune cells.
Interleukins are highly effective proteins that trigger fever, inflammation and a range of other immune reactions even in the smallest of quantities, thus boosting the body's defense against pathogens.
If the glycosylasparaginase on the fungal spores is missing, the immune system can release more of this inflammatory substance. Immune cells are activated and are better able to fight off the fungus. Conversely, this indicates that the glycosylasparaginase produced by the fungus normally helps to dampen the immune response. This allows the fungus to infect the body almost unhindered.
The study in the mouse model supports this hypothesis: in mice with an intact immune system, the fungus was attacked more strongly by the immune system when the gene for glycosylasparaginase was previously switched off.
"The glycosylasparaginase on the spores of Aspergillus fumigatus therefore plays a role in the fight against the immune system. However, we cannot yet say exactly how this mechanism works," says Kniemeyer, summarizing the results of the study.
The findings can help to develop new therapies for infections with Aspergillus fumigatus. This is urgently needed, as there are currently only a few effective drugs to combat fungal infections and resistance to them is gradually spreading.
The research work is a demonstration of successful cooperation between institutes and clinics in several countries. In addition to the Brazilian and German researchers, British and U.S. colleagues also contributed significantly to the new findings.
More information: Camila Figueiredo Pinzan et al, Aspergillus fumigatus conidial surface-associated proteome reveals factors for fungal evasion and host immunity modulation, Nature Microbiology (2024). DOI: 10.1038/s41564-024-01782-y
Provided by Leibniz-Institut für Naturstoff-Forschung und Infektionsbiologie - Hans-Knöll-Institut (Leibniz-HKI)
Citation: Fungal spores of the mold Aspergillus fumigatus produce an enzyme that weakens the immune system (2024, September 4) retrieved 4 September 2024 from https://phys.org/news/2024-09-fungal-spores-mold-aspergillus-fumigatus.html
This document is subject to copyright. Apart from any fair dealing for the purpose of private study or research, no part may be reproduced without the written permission. The content is provided for information purposes only.